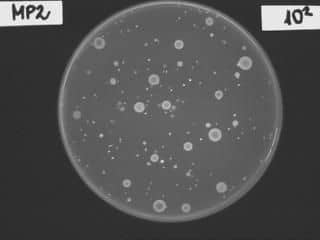

A törzsfejlődés során a szervezetek bonyolultabbá válásával lett immunrendszerünk is egyre összetettebb. Már a primitív többsejtűekben is léteznek sejtek, amelyek arra hivatottak, hogy felfalják az idegen sejteket, baktériumokat.Ezeknek a sejteknek a leszármazottait nevezzük a fejlett szervezetekben a természetes, ősi immunrendszer sejtjeinek, ezek a falósejtek, illetve ölő sejtek. Felismerik a saját sejteket, de az idegeneket válogatás nélkül legyilkolják, ezért nem specifikus immunitásnak is nevezzük ezt a védekezési formát. A későbbiekben a gerincesekben szerveződik egy bonyolultabb, adaptív (alkalmazkodó) immunválasz, melyben ellenanyagok képződnek, ezek az ellenanyagok sokfélék, és csak a megfelelő, specifikus ellenségeket támadják. Ez a fajta immunitás már emlékezésre is képes. Léteznek olyan sejtek, amelyek életünk végéig emlékeznek a már egyszer észlelt kórokozóra, ismételt találkozáskor nagy mennyiségű specifikus ellenanyag képződhet néhány órán belül. Ezek az emlékező sejtek az allergiás reakciókban is jelen vannak.Az immunrendszernek tehát vannak sejtes és nem sejtes elemei.A sejtes elemek egy közös őssejtből fejlődnek két fő irányba. Az egyik a limfoid irány, amely az adaptív immunrendszer B és T sejtjeit jelenti.A másik a mieloidnak nevezett út, ahol a vér alakos elemei, a falósejtek és egyéb fehérvérsejtek, valamint az antigén bemutató sejtek differenciálódnak.A sejtek egymással vegyi úton kommunikálnak. Ez azt jelenti, hogy jellegzetes anyagokat termelnek és választanak ki magukból, amelyek aztán a neki megfelelő érzékeny másik sejtben reakciót hoznak létre. Ez például idegsejtek esetén az úgynevezett ingerületátvivő anyag, ami részben a másik idegsejtet vagy egyéb, például izom- vagy nyáktermelő sejtet késztet működésre.A fehérvérsejtek esetében ezeket az egymást figyelmeztető, segítő vagy gátló anyagokat citokineknek nevezzük, de kiválasztódnak egyéb jeladó mediátorok, mint a gyulladáskeltő prosztaglandinok és ingerületátvivők, mint a kulcsfontosságú hísztainin vagy bradikinin.
Kapcsolódó fórumok:
- muslinca keletkezése
Hozzászólások (0)
Jelentkezz be, hogy hozzászólhass!
BejelentkezésMég nincs hozzászólás.
Legyél az első, aki hozzászól!